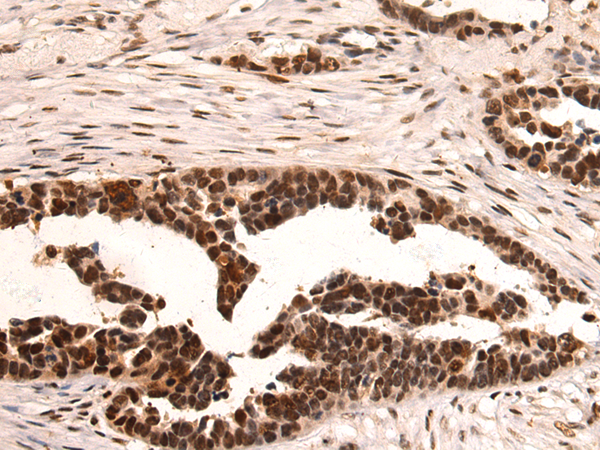
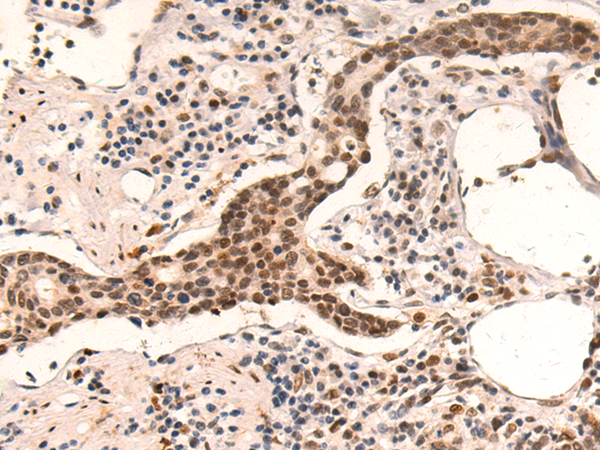
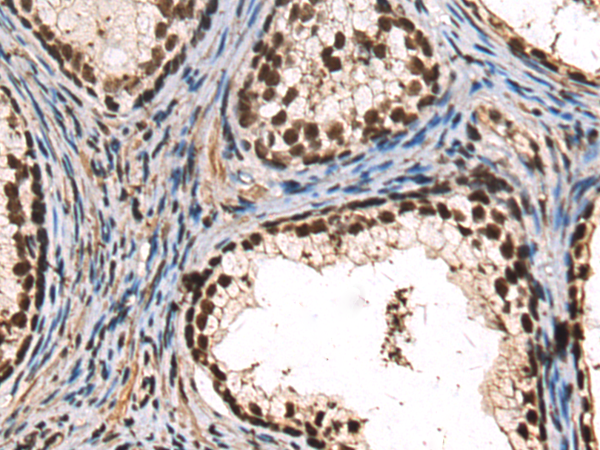
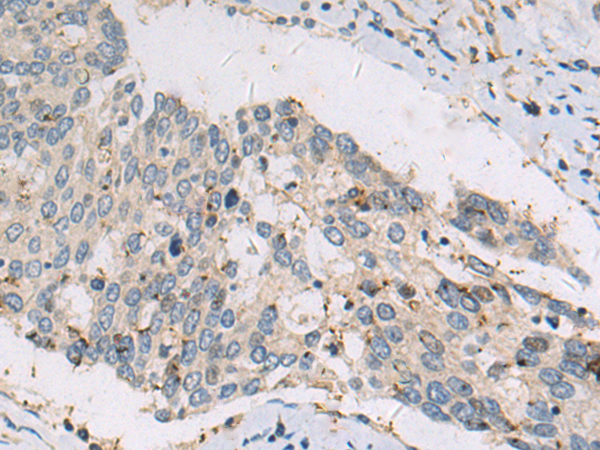
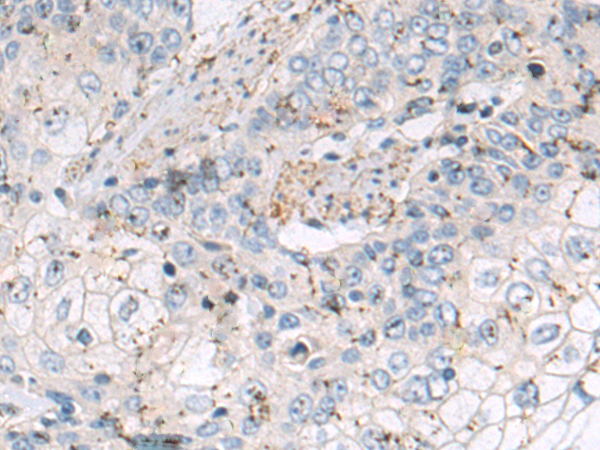

-
分类: 科研抗体货号: P10614别名: RIF; ARHF应用: WB,IHC反应种属: Human, Mouse
-
分类: 科研抗体货号: P10598别名: RCH2; SRP1; IPOA5; NPI-1应用: IHC反应种属: Human, Mouse, Rat
-
分类: 科研抗体货号: P10607别名: Prp5; PRPF5应用: IHC反应种属: Human, Mouse, Rat
-
分类: 科研抗体货号: P10606别名:应用: WB,IHC反应种属: Human
-
分类: 科研抗体货号: P10612别名: AMY-1应用: IHC反应种属: Human, Mouse
-
分类: 科研抗体货号: P10623别名: CSN6; MOV34-34KD应用: WB反应种属: Human, Mouse
-
分类: 科研抗体货号: P10611别名: PDF; PFD1应用: IHC反应种属: Human, Mouse
-
分类: 科研抗体货号: P10605别名: CMT2Q; AMOXAD应用: IHC反应种属: Human, Rat
-
分类: 科研抗体货号: P10622别名: OI14; TRICB; TRIC-B; C9orf87; D4Ertd89e; bA219P18.1应用: WB,IHC反应种属: Human
-
分类: 科研抗体货号: P10610别名: LIP1; LIP.1; LIPRIN应用: IHC反应种属: Human

鄂公网安备42018502007531号
鄂公网安备42018502007531号

